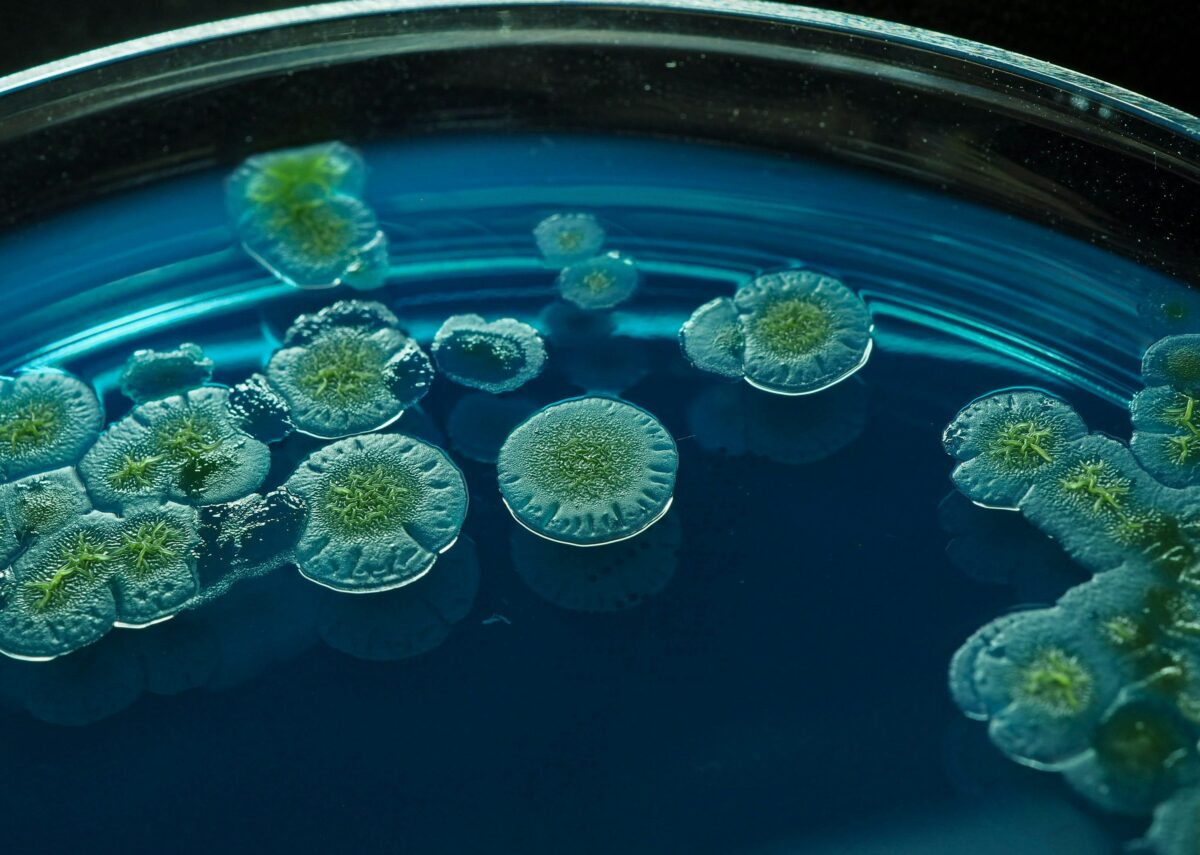

Abstract Bacillus thuringiensis (Bt) has emerged as a cornerstone of sustainable pest management, celebrated as a “green” microbial insecticide in agriculture. This review provides a...
Overview of the Microbe Ampelomyces quisqualis is a filamentous fungus known as a mycoparasite, meaning it parasitizes other fungi. It was first described in the...
01
Overview of the Microbe Metarhizium anisopliae is a globally distributed, filamentous, asexual, soil-dwelling fungus...
02
Overview of the Microbe Azospirillum amazonense was first isolated from the Amazonian rice rhizosphere...
03
Bacillus subtilis is a robust, Gram-positive bacterium widely recognized for its adaptability and efficiency in...
04
Gain insights into the mind of a visionary leader, where innovative ideas and transformative...
05
Overview of the Microbe Pseudomonas stutzeri is a motile, rod‑shaped, non‑spore‑forming Gram‑negative bacterium first...
01
Overview of the Microbe Klebsiella pneumoniae is a Gram-negative, facultative anaerobic, rod-shaped bacterium belonging...
02
Overview of the Microbe Penicillium bilaiae (often spelled P. bilaii) is a filamentous soil...
03
Overview of the Microbe Lecanicillium longisporum, formerly classified under Verticillium lecanii, is a globally...
04
05
Bacillus subtilis is a robust, Gram-positive bacterium widely recognized for its adaptability and efficiency in...
01
A pioneering industrial microbiologist who bridges food science and sustainability. Renowned for work in...
02
Overview of the Microbe Taxonomy and Strain Information Beijerinckia mobilis belongs to the domain...
03
Overview of the Microbe Pseudomonas putida KT2440 is a non‑spore‑forming, motile, Gram‑negative bacterium isolated...
04
Bacillus subtilis is a robust, Gram-positive bacterium widely recognized for its adaptability and efficiency in...
05
Agrobacterium radiobacter is a rod‑shaped, motile, Gram‑negative bacterium widely distributed in soil and the...
06
Overview of the Microbe Gliocladium virens (teleomorph: Trichoderma virens) is a filamentous, soil-dwelling fungus...
07
Overview of the Microbe Herbaspirillum seropedicae is a nitrogen-fixing, β-proteobacterial endophyte belonging to the...
08
Bacillus subtilis is a robust, Gram-positive bacterium widely recognized for its adaptability and efficiency in...
Overview of the Microbe Ampelomyces quisqualis is a filamentous fungus known as a mycoparasite, meaning it parasitizes other fungi. It was first described in the...
A pioneering expert in microbiological innovation, she specializes in applied and environmental microbiology, electromicrobiology, geomicrobiology, bioremediation, and synthetic biology. Her work advances sustainable solutions across ecosystems and industries, harnessing microbial processes to address pressing challenges in environmental health, energy, and biotechnology.
American environmental microbiologist and scientific administrator, known for her research on global infectious diseases, water, and health, and for her pioneering work as the first female director of the National Science Foundation (NSF).
Widely recognized as the pioneer of Green Microbiology, she integrates science and sustainability to champion eco-innovative microbial solutions—advancing health, transforming industries, and driving global environmental progress.
A pioneering expert in microbiological innovation, she specializes in applied and environmental microbiology, electromicrobiology, geomicrobiology, bioremediation, and synthetic biology. Her work advances sustainable solutions across ecosystems and industries, harnessing microbial processes to address pressing challenges in environmental health, energy, and biotechnology.
American environmental microbiologist and scientific administrator, known for her research on global infectious diseases, water, and health, and for her pioneering work as the first female director of the National Science Foundation (NSF).
Overview of the Microbe Metarhizium anisopliae is a globally distributed, filamentous, asexual, soil-dwelling fungus classified under the family Clavicipitaceae, order Hypocreales [1]. First described by...
Overview of the Microbe Lecanicillium longisporum, formerly classified under Verticillium lecanii, is a globally distributed, filamentous entomopathogenic fungus in the order Hypocreales and family Cordycipitaceae...
A pioneering industrial microbiologist who bridges food science and sustainability. Renowned for work in food safety, she develops innovative solutions for sustainable food systems, industrial practices, and microbial research.
Overview of the Microbe Herbaspirillum seropedicae is a nitrogen-fixing, β-proteobacterial endophyte belonging to the family Oxalobacteraceae. Initially described as Pseudomonas rubrisubalbicans by Leifson in 1962...
Overview of the Microbe Ampelomyces quisqualis is a filamentous fungus known as a mycoparasite, meaning it parasitizes other fungi. It was first described in the...
Bacillus subtilis is a robust, Gram-positive bacterium widely recognized for its adaptability and efficiency in various environments.
Bacillus subtilis is a robust, Gram-positive bacterium widely recognized for its adaptability and efficiency in various environments.
Overview of the Microbe Paenibacillus polymyxa is a gram-positive, rod-shaped, spore-forming bacterium commonly found in soil and the rhizosphere of plants. It thrives in diverse...
Agrobacterium radiobacter is a rod‑shaped, motile, Gram‑negative bacterium widely distributed in soil and the root microbiome of dicotyledonous plants
Bacillus subtilis is a robust, Gram-positive bacterium widely recognized for its adaptability and efficiency in various environments.
Bacillus subtilis is a robust, Gram-positive bacterium widely recognized for its adaptability and efficiency in various environments.
Overview of the Microbe Paenibacillus polymyxa is a gram-positive, rod-shaped, spore-forming bacterium commonly found in soil and the rhizosphere of plants. It thrives in diverse...
Agrobacterium radiobacter is a rod‑shaped, motile, Gram‑negative bacterium widely distributed in soil and the root microbiome of dicotyledonous plants
Overview of the Microbe Taxonomy and Morphology Bacillus mucilaginosus (synonymously known as Paenibacillus mucilaginosus in some classifications) is a rod‐shaped, facultatively anaerobic bacterium belonging to the...
Overview of the Microbe Coniothyrium minitans, also known by the synonym Paraphaeosphaeria minitans, is an ascomycete fungus in the family Didymosphaeriaceae [1]. This obligate mycoparasite...
Overview of the Microbe B. amyloliquefaciens belongs to the Bacillus subtilis species complex and was first described by Priest et al. in 1987 based on...
Overview of the Microbe Taxonomy and Strain Information Beijerinckia mobilis belongs to the domain Bacteria, phylum Pseudomonadota, class Alphaproteobacteria, order Hyphomicrobiales, and family Beijerinckiaceae[3]. The...
Bacillus subtilis is a robust, Gram-positive bacterium widely recognized for its adaptability and efficiency in various environments.
Agrobacterium radiobacter is a rod‑shaped, motile, Gram‑negative bacterium widely distributed in soil and the root microbiome of dicotyledonous plants
Overview of the Microbe B. amyloliquefaciens belongs to the Bacillus subtilis species complex and was first described by Priest et al. in 1987 based on...
Overview of the Microbe Taxonomy and Strain Information Beijerinckia mobilis belongs to the domain Bacteria, phylum Pseudomonadota, class Alphaproteobacteria, order Hyphomicrobiales, and family Beijerinckiaceae[3]. The...
Bacillus subtilis is a robust, Gram-positive bacterium widely recognized for its adaptability and efficiency in various environments.
Agrobacterium radiobacter is a rod‑shaped, motile, Gram‑negative bacterium widely distributed in soil and the root microbiome of dicotyledonous plants